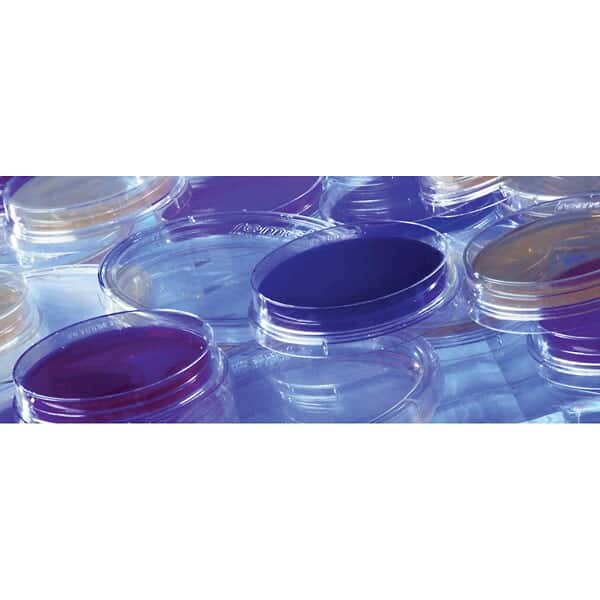
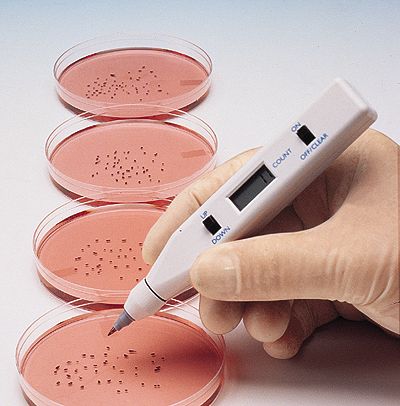

Cole-Parmer 검색
Cole-Parmer의 전 상품을 검색하실 수 있습니다.

- 번호
-
- Cat. No
- Model
- Description
- Unit
- Price(VAT별도)
- 재고
- 주문
- 55116

- CO.1420764
- 14207-64
- CONTACT I TSA W/BLD AGAR 20PK/Prepared Contact I Plates, TSA Blood Agar 5%; 20/Pk/
- 1/PK
- 문의
- 15 Day

- 55115

- CO.1420766
- 14207-66
- CONTACT I TSA LEC&POLY 20PK/Prepared Plates, TSA w/Lecithin/Polysorbate Agar; 20/Pk/
- 1/PK
- 소비자가 : 652,500원
- 15 Day

- 55114

- CO.1420770
- 14207-70
- STERILE CONTACT TSA W/W 10PK/Sterile Plates, TSA Lec/Poly 80 Agar; 10/Pk/
- 1/PK
- 소비자가 : 672,400원
- 15 Day

- 55113
- CO.1420772
- 14207-72
- STER CONT SAB DEX W/W 10PK/Sterile Contact Plates, Sabouraud Dextrose Lec/Poly Agar; 10/Pk/
- 1/PK
- 문의
- 15 Day

- 55112

- CO.1420780
- 14207-80
- FLUID D 100ML 10/PK/Prepared Bottle, Fluid D Peptone/Polysorbate, 100 mL; 10/Pk/
- 1/PK
- 문의
- 15 Day

- 55111

- CO.1420782
- 14207-82
- LACTOSE BROTH 90 ML 10/CS/Lactose broth bottled medium, 90 mL, lug cap, 10/pack/
- 1/CS
- 문의
- 15 Day

- 55110

- CO.1420784
- 14207-84
- FLUID A 1000 ML/Prepared Bottle, Fluid A Peptone, 1000 mL; 1/ea/
- 1/EA
- 문의
- 15 Day

- 55109

- CO.1420786
- 14207-86
- R2A AGAR 200 ML 10/CS/R2A agar bottled medium, 200 mL, borosilicate glass, 10/pack/
- 1/CS
- 문의
- 15 Day

- 55108

- CO.1420788
- 14207-88
- STD METHODS AGAR 200ML 10CS/Prepared Glass Bottles, Plate Count Agar, 200 mL; 10/Pk/
- 1/CS
- 문의
- 15 Day

- 55107

- CO.1420792
- 14207-92
- POTATO DEXTROSE AGAR 10/PK/Potato dextrose agar, pH 5.6, 10/pk/
- 1/PK
- 소비자가 : 429,500원
- 15 Day

- 55106

- CO.1420794
- 14207-94
- SAB DEX AGAR (PH 5.6) 10/PK/Sabouraud dextrose agar, pH 5.6, 10/pk/
- 1/PK
- 소비자가 : 361,300원
- 15 Day

- 55105

- CO.1420800
- 14208-00
- INDOLE(KOVACS) REAGENT 25ML/Indole (kovacs) Reagent bottled medium, 25 mL/
- 1/EA
- 문의
- 15 Day

- 55104

- CO.1420802
- 14208-02
- INFUSION AGAR BRAIN HRT 10PK/Prepared Glass Bottles, BHI Agar, 500 mL; 4/Pk/
- 1/PK
- 문의
- 15 Day

- 55103

- CO.1420804
- 14208-04
- INFUSION AGAR BRAIN HRT 10PK/Prepared Bottles, Brain Heart Inf (BHI) Agar, 500 mL; 10/Pk/
- 1/PK
- 문의
- 15 Day

- 55102

- CO.1420806
- 14208-06
- FLUID THIOGLYCOLLATE 10PK/Prepared Bottles, Fluid Thioglycollate, 500 mL; 10/Pk/
- 1/PK
- 문의
- 15 Day

- 55101

- CO.1420808
- 14208-08
- CENTRIMIDE AGAR SELEC 10PK/Prepared Bottles, Centrimide Selective Agar, 500 mL; 10/Pk/
- 1/PK
- 문의
- 15 Day

- 55100

- CO.1421000
- 14210-00
- REPLICA PLATING TOOL
- 1/EA
- 소비자가 : 418,200원
- 15 Day

- 55099

- CO.1421050
- 14210-50
- VELVETEEN SQUARES 36/BOX
- 1/CS
- 소비자가 : 407,600원
- 15 Day

- 55098
- CO.1421150
- 14211-50
- REPLACEMENT TIP BLACK
- 1/EA
- 소비자가 : 94,800원
- 15 Day

- 55097

- CO.1421200
- 14212-00
- CELL SPREADER BACTERIAL 16MM
- 1/EA
- 소비자가 : 55,600원
- 15 Day

- 55096

- CO.1421202
- 14212-02
- CELL SPREADER BACTERIAL 25MM
- 1/EA
- 소비자가 : 51,600원
- 15 Day

- 55095

- CO.1421203
- 14212-03
- COLONY COUNTER/Colony counter, handheld, battery-operated/
- 1/EA
- 소비자가 : 870,900원
- 15 Day

- 55094

- CO.1421204
- 14212-04
- COLONY COUNTER DIGITAL 230V
- 1/EA
- 소비자가 : 2,363,900원
- 15 Day

- 55093

- CO.1421205
- 14212-05
- REPL FELTTIP PEN RED
- 1/EA
- 문의
- 15 Day

- 55092

- CO.1421206
- 14212-06
- COLNY COUNTR DIGITL IQOQ 230V
- 1/EA
- 소비자가 : 4,598,000원
- 15 Day

- 55091

- CO.1421207
- 14212-07
- REPL FELTTIP PEN BLK
- 1/EA
- 문의
- 15 Day

- 55090

- CO.1421209
- 14212-09
- BATTERY 3V F/14212-01/-03/Replacement battery for colony counter/
- 1/EA
- 문의
- 15 Day

- 55089

- CO.1421253
- 14212-53
- COUNTING GRID 5/PK
- 1/EA
- 문의
- 15 Day

- 55088

- CO.1421255
- 14212-55
- AC ADAPTER F/14212-01
- 1/EA
- 문의
- 15 Day

- 55087

- CO.1421260
- 14212-60
- MAGNIFIER COLNY CNTR 1.7X
- 1/EA
- 소비자가 : 292,600원
- 15 Day
